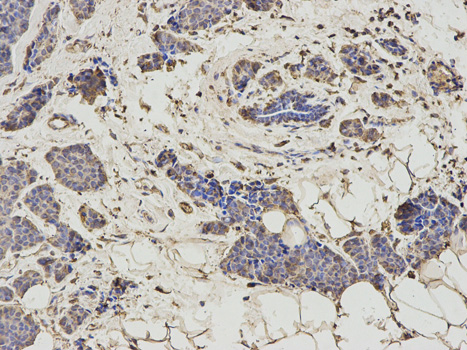

Anti-HNMT Antibody
A30572
ApplicationsImmunoFluorescence, Western Blot, ImmunoHistoChemistry
Product group Antibodies
ReactivityHuman, Mouse, Rat
Overview
- SupplierAntibodies.com
- Product NameAnti-HNMT Antibody
- Delivery Days Customer7
- ApplicationsImmunoFluorescence, Western Blot, ImmunoHistoChemistry
- CertificationResearch Use Only
- ClonalityPolyclonal
- ConjugateUnconjugated
- Estimated Purity>95%
- HostRabbit
- Scientific DescriptionRabbit polyclonal antibody to HNMT
- ReactivityHuman, Mouse, Rat
- UNSPSC12352203